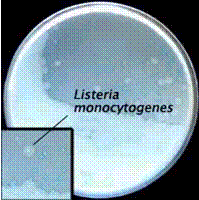
李斯特氏單胞菌屬

李斯特氏單胞菌屬菌種來源
土壤、水體、蔬菜、海水沉積物、動物腸道相關食物
未經巴氏殺菌的牛乳、軟乳酪、生肉和家禽、熱狗、午餐肉、冷藏即食快餐、生蔬菜(如果施用含生物的糞肥)相關詞條
單核細胞增生菌屬病原菌
食源性細菌
巴氏殺菌
李斯特氏單胞菌屬(Listeriamon ocytogen /%5Bcn
李斯特氏單胞菌屬李斯特氏菌屬有7個菌種,即單核細胞增生李斯特氏菌,綿羊李斯特氏菌,英諾克李斯特氏菌,威爾斯李斯特氏菌 ,西爾李斯特氏菌 ,格氏李斯特氏菌 ,莫氏李斯特氏菌
基本信息 生化反應單核細胞增生李斯特氏菌(Listeria monocytogenes)簡稱單增李斯特菌,是一種人畜共患病的病原菌。它能引起人畜的李氏菌的病,感染後主要表...
生物學特性 流行病學 檢測方法 致病性利斯特菌病(也稱為李氏桿菌或利斯特氏桿菌)是一種因為吃了利斯特菌污染的食物,而患上的嚴重傳染病。利斯特菌存在於世界範圍的環境中,在鳥類、蜘蛛、甲殼類動物...
概述 病菌特點 病菌的菌株 病原學 主要病因推薦羅氏染色法細胞化學染色法髓過氧化物酶嗜中性細胞鹼性磷酸酶酯酶酸性磷酸酶和抗酒石酸酸性磷酸酶高碘酸雪夫氏反應糖原染色...性貧血骨髓異常增生綜合徵惡性組織細胞病何杰金氏病骨髓瘤...
內容介紹 作品目錄phage 133) 8t(8t) 氣單孢菌噬菌體Aeh1(Aeromonas phage Aeh1) 氣單孢菌噬菌體65(Aeromonas...(Acinetobacter phage E5) 氣單孢菌噬菌體1(Aeromonas...
分類類型 分類 有尾噬菌體目成員 有尾噬菌體目基本特性陽性、陰性需氧菌及厭氧菌:革蘭氏陽性需氧菌芽胞桿菌屬、白喉棒狀桿菌、液化腸球菌、鳥腸球菌、單核細胞增生李斯特氏菌、乳桿菌屬、星形諾卡菌、金黃色...不動桿菌、嗜水氣單胞菌、溫和氣單胞菌、豚鼠氣單胞菌、糞產鹼桿菌、支氣管炎博...
成份 性狀 適應症 規格 用法用量,腸桿菌,變形桿菌屬,假單胞菌屬,嗜血桿菌屬,布蘭漢氏菌屬,軍團菌和...氏菌、弧菌、氣單胞菌、類志貿鄰單胞菌、出血敗血性巴斯德菌、嗜血桿菌、空腸...、李斯特菌、棒狀桿菌、衣原體屬。下列細菌敏感性變異大:不動桿菌、鞘膜加德鈉...
藥理作用 動力學 適應症 用法用量 不良反應在分類學、生理學和經濟價值上非常重要的農業微生物,例如:胡蘿蔔歐文氏菌、植物致病性假單胞菌以及我國正在開展的黃單胞菌的研究等正在進行之中。 植物固氮...Woese等發現了地球上的第三生命形式-古菌,才導致了生命三域學說的誕生...
發現歷史 分類學地位 具體分類 特點 化學組成